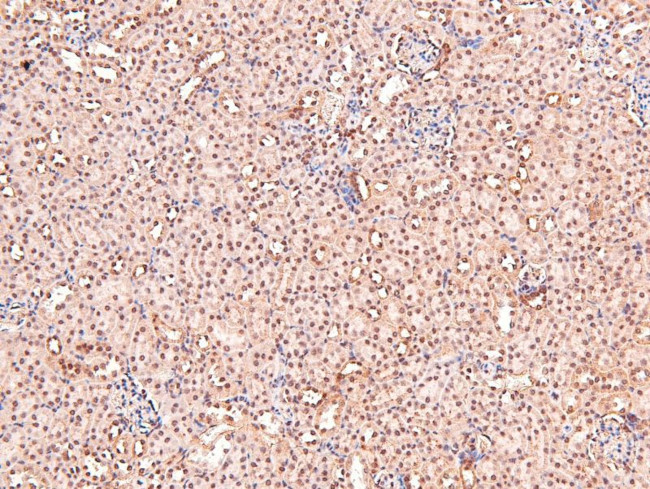
Phospho-CRMP1 (Tyr504) Antibody in Immunohistochemistry (Paraffin) (IHC (P))

Search
Invitrogen
Phospho-CRMP1 (Tyr504) Polyclonal Antibody
{{$productOrderCtrl.translations['antibody.pdp.commerceCard.promotion.promotions']}}
{{$productOrderCtrl.translations['antibody.pdp.commerceCard.promotion.viewpromo']}}
{{$productOrderCtrl.translations['antibody.pdp.commerceCard.promotion.promocode']}}: {{promo.promoCode}} {{promo.promoTitle}} {{promo.promoDescription}}. {{$productOrderCtrl.translations['antibody.pdp.commerceCard.promotion.learnmore']}}
图: 1 / 6
Phospho-CRMP1 (Tyr504) Antibody (PA5-105983) in IHC (P)






Please note: We are reviewing Western blot images included in the antibody testing data in our catalog, including those provided by third parties. Unless expressly labeled or annotated as “raw-unedited”, Western blot images included in the antibody testing data in our catalog may have been edited, optimized or otherwise adjusted for presentation.
产品信息
PA5-105983
种属反应
宿主/亚型
分类
类型
抗原
偶联物
形式
浓度
规格
纯化类型
保存液
内含物
保存条件
运输条件
RRID
产品详细信息
Antibody detects endogenous levels of CRMP-1 only when phosphorylated at Tyr504.
靶标信息
Collapsin-response mediator proteins (CRMPs) are highly expressed in the developing brain where they play major roles in axonal outgrowth, neurite differentiation, and apoptosis. Their continued expression in areas of high synaptic remodeling such as the cerebellum, hippocampus, and the olfactory system suggests that these proteins may also be involved in adult brain plasticity. CRMP-1 was initially identified as a dihydro-pyrimidinase expressed exclusively in brain; later studies have shown that it is involved with neurotrophin (NT) 3-induced neurite formation and outgrowth. CRMP-1 localization switches from axonal to somatodendritic when neurons reach functional maturity, suggesting that it is involved in early neuronal differentiation as well as in later processes related to the survival or death of the newly generated neurons.
仅用于科研。不用于诊断过程。未经明确授权不得转售。
篇参考文献 (0)
生物信息学
蛋白别名: Collapsin response mediator protein 1; CRMP-1; Dihydropyrimidinase-related protein 1; DRP-1; Inactive dihydropyrimidinase; ULIP-3; Unc-33-like phosphoprotein 3
基因别名: CRMP-1; CRMP1; DPYSL1; DRP-1; ULIP-3; ULIP3
UniProt ID: (Rat) Q62950, (Mouse) P97427
Entrez Gene ID: (Rat) 25415, (Mouse) 12933